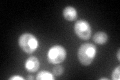
YER110C
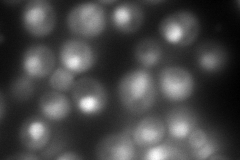
YER110C
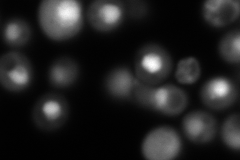
YER110C
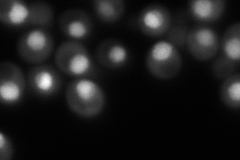
YER110C
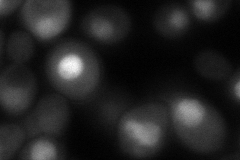
YER110C
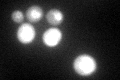
YER110C

View description
Karyopherin beta, mediates nuclear import of ribosomal proteins prior to assembly into ribosomes and import of histones H3 and H4; localizes to the nuclear pore, nucleus, and cytoplasm; exhibits genetic interactions with RAI1
Localization:
Intensity:
Fold change:
Significance:
-
C’ GFP library in SD
nucleus, cytosol112.76 -
N' NOP1pr-GFP in SD
nucleus390.887 -
N' TEF2pr-mCherry in SD
nucleus314.708 -
N' NATIVEpr-GFP in SD
nucleus225.1 -
N' TEF2pr-VC and Cyto-VN in SD
nucleus96.4008 -
C’ GFP library in SD+DTT
nucleus, cytosol86.710.76No -
C’ GFP library in SD+H2O2

cytosolN/AN/ANo -
C’ GFP library in Starvation Media

nucleus, cytosol62.560.55Yes -
C’ GFP library on the background of Pup2-DaMP

nucleus, cytosol -
C’ GFP library on the background of CCT mutant

nucleus, cytosol121.8361.08044No
